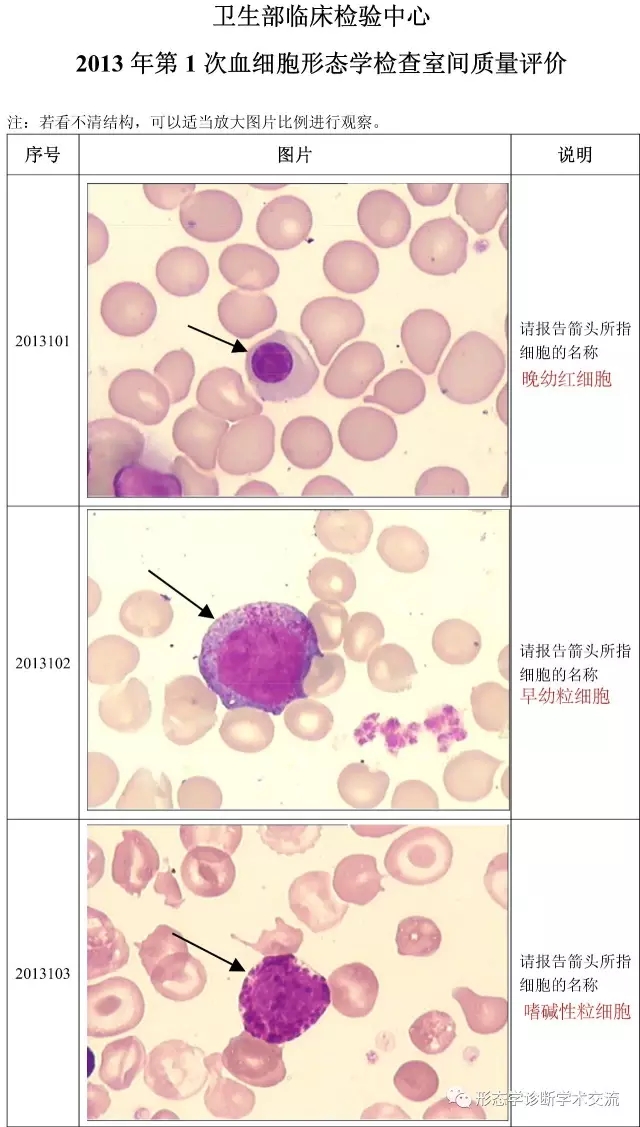
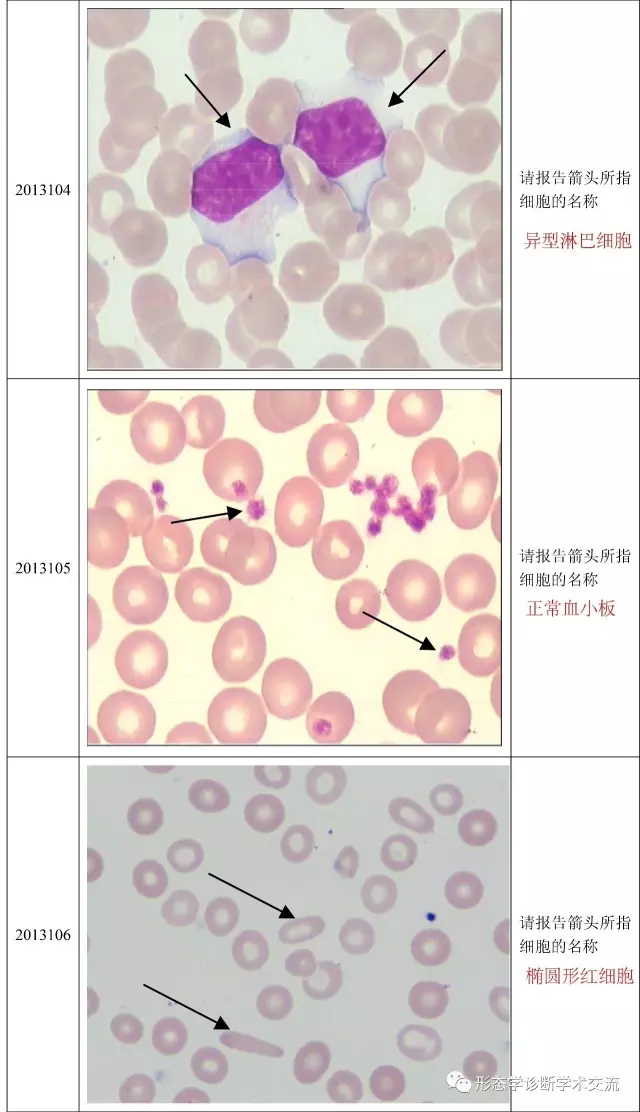
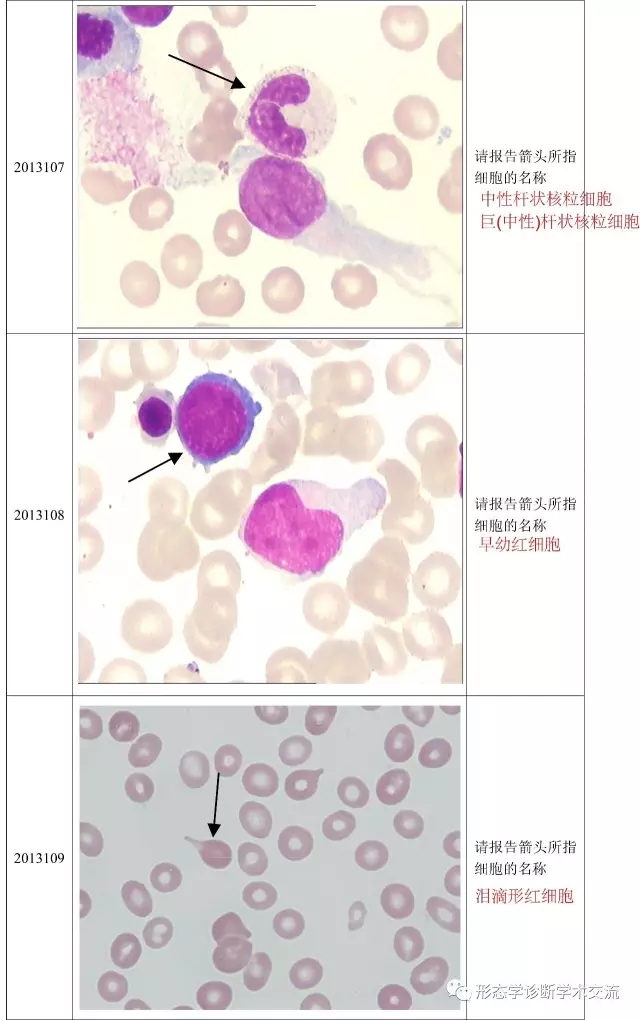
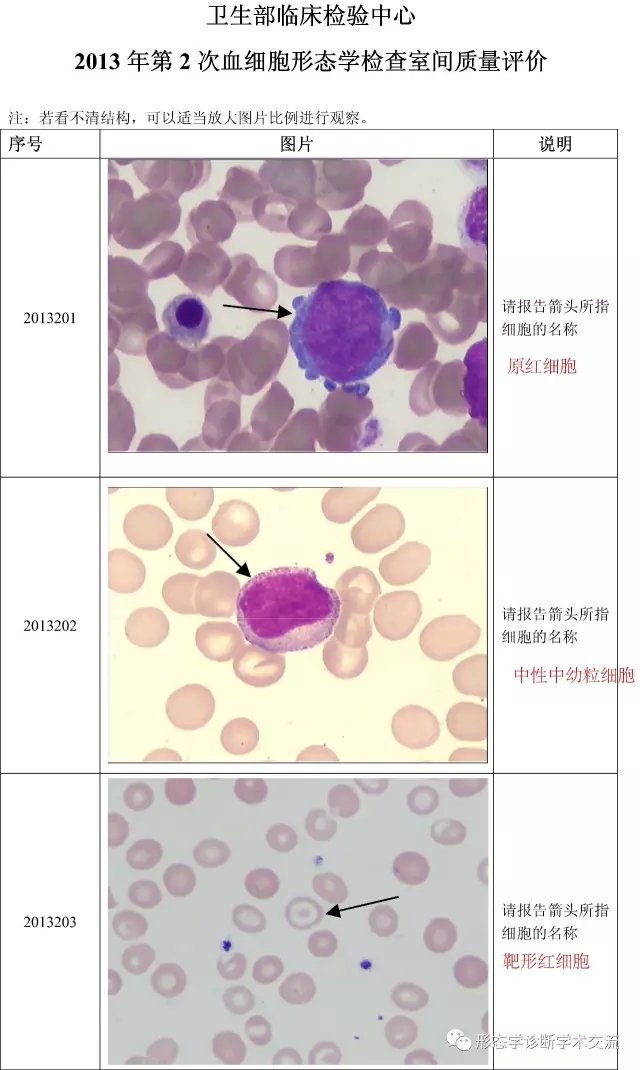
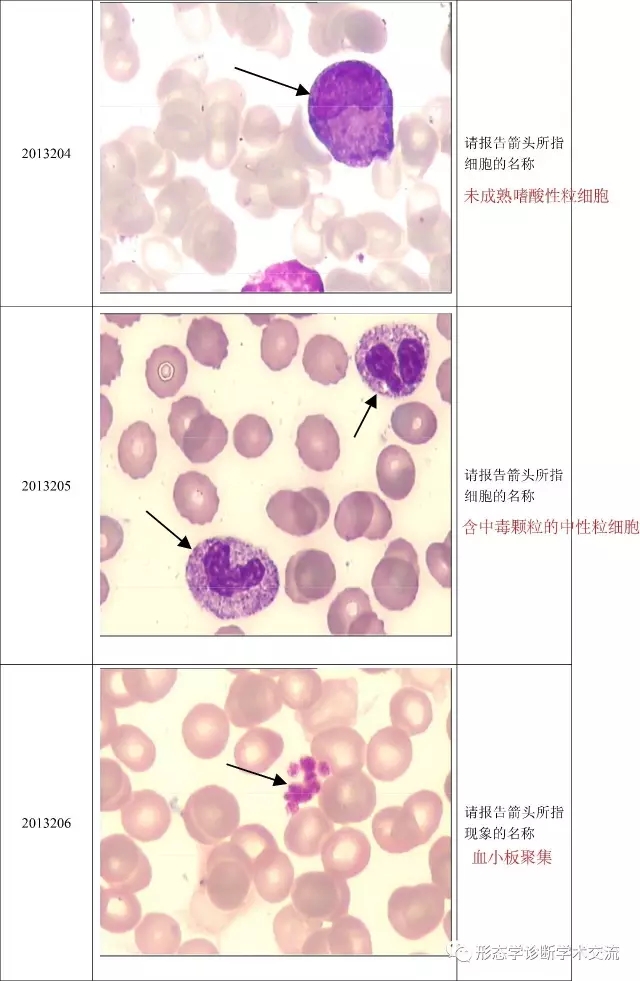
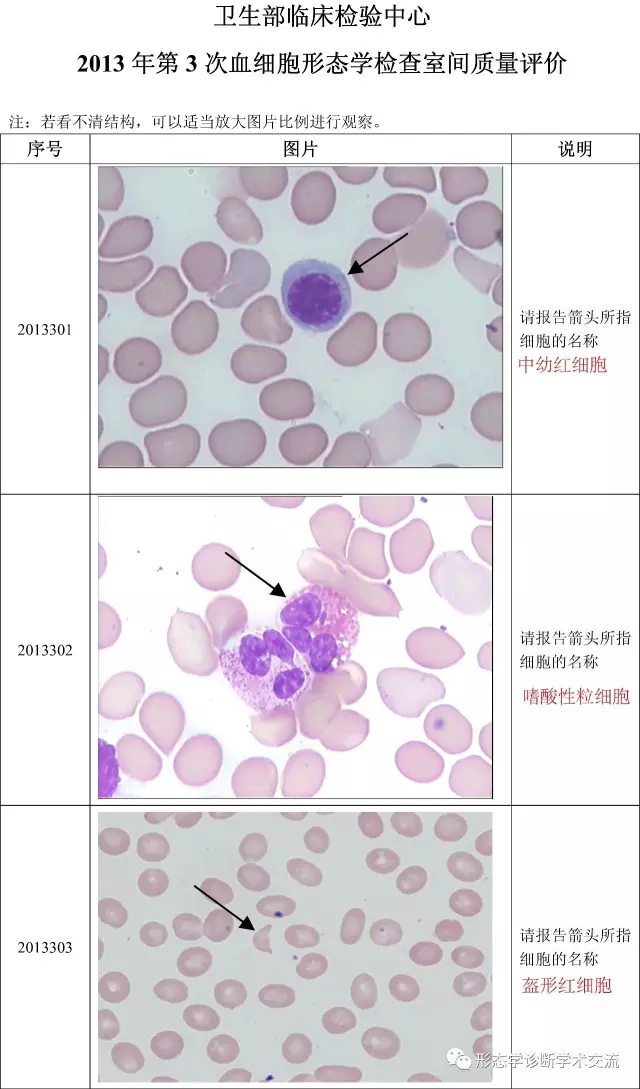
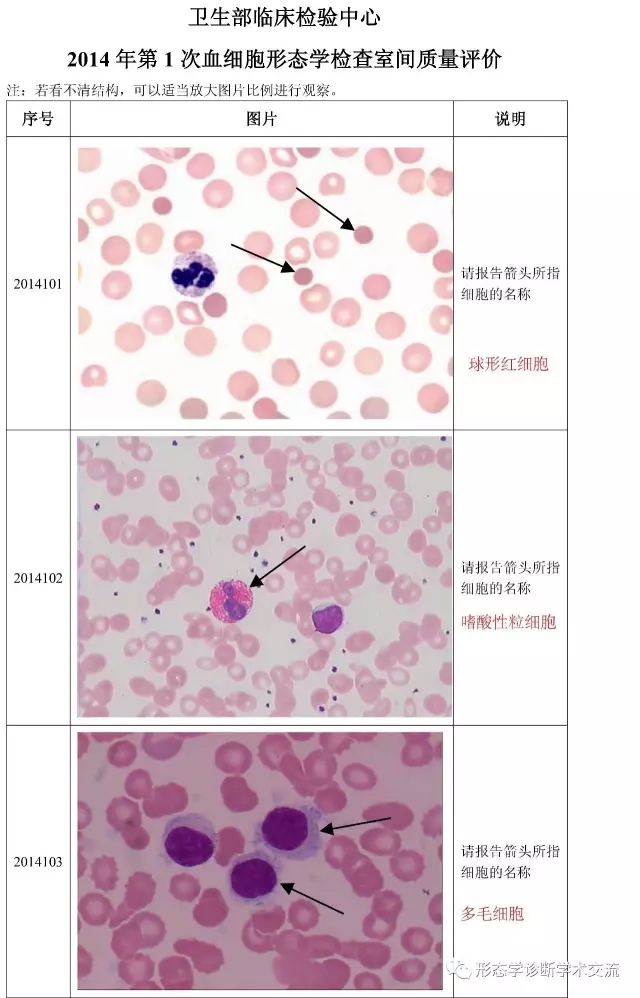
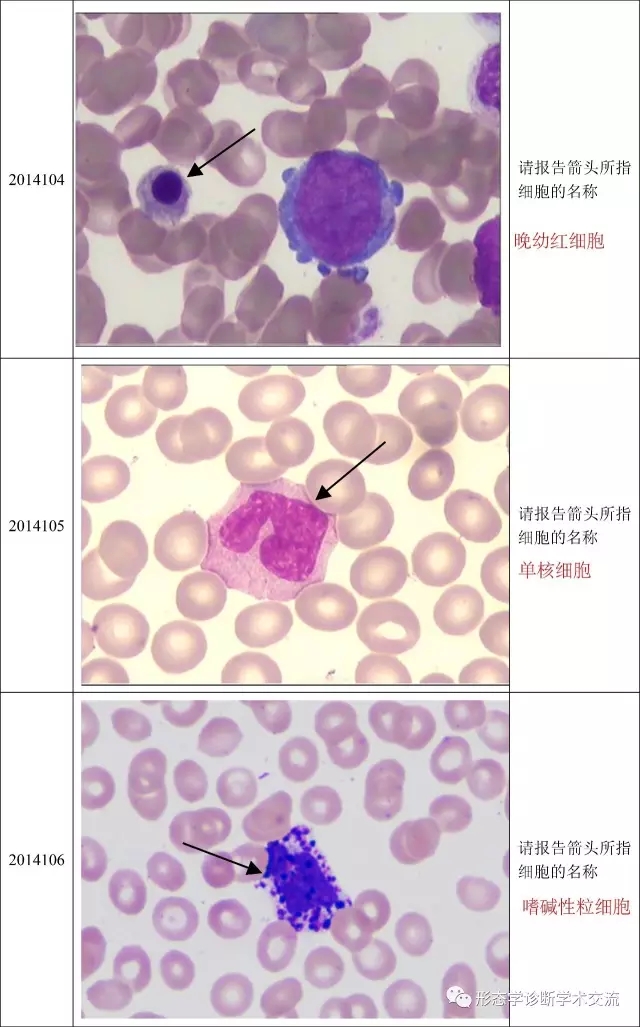
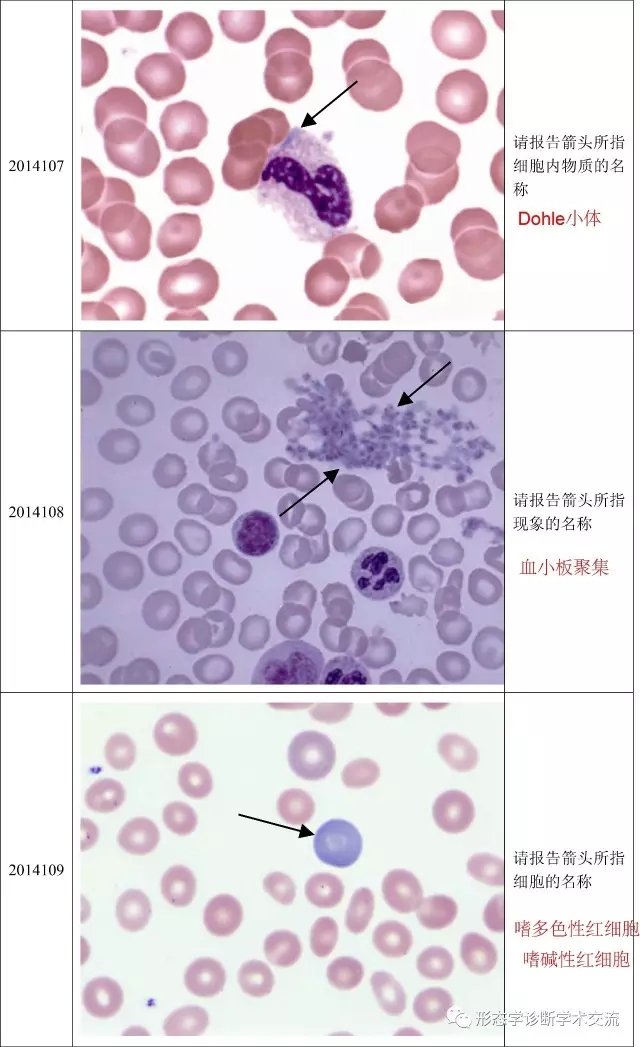
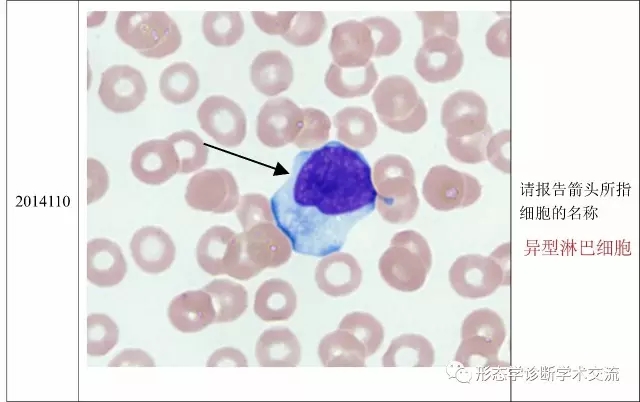
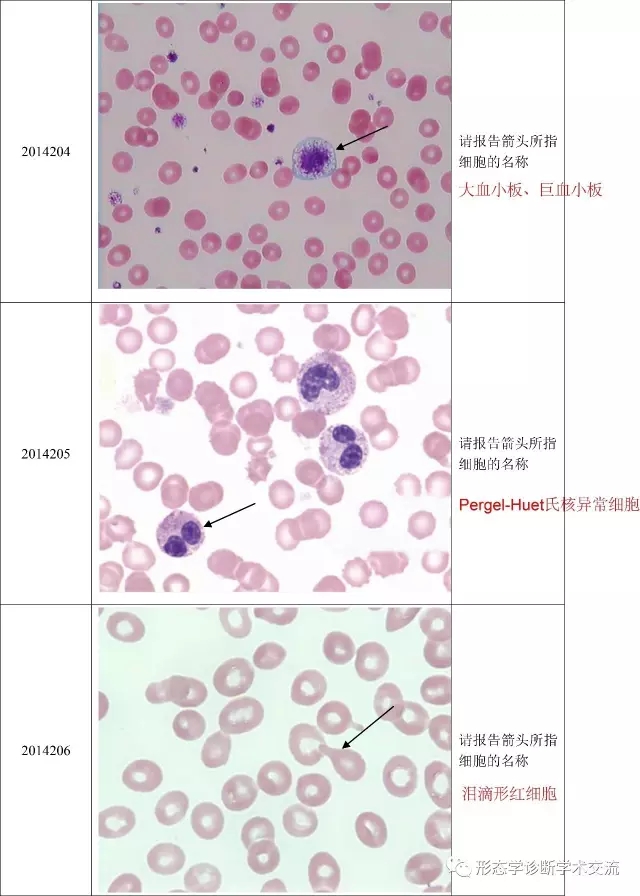
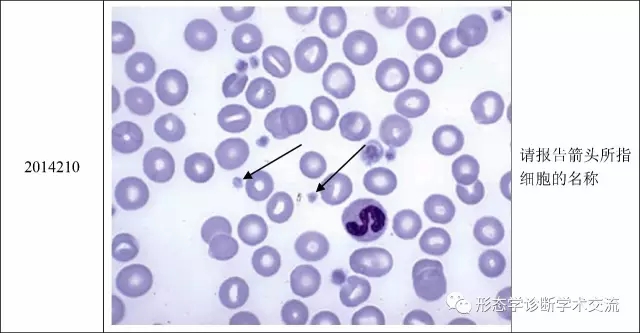
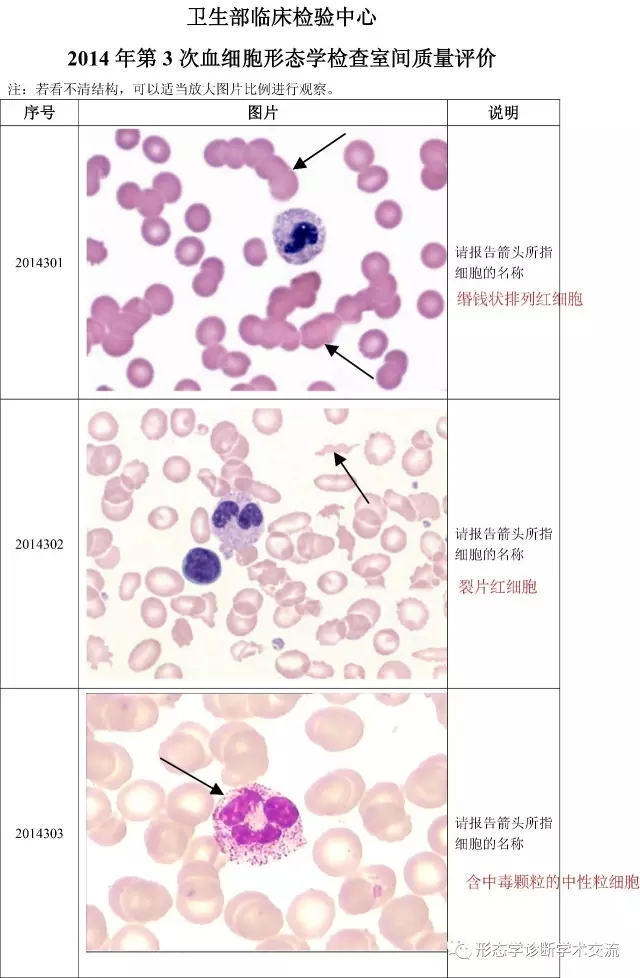
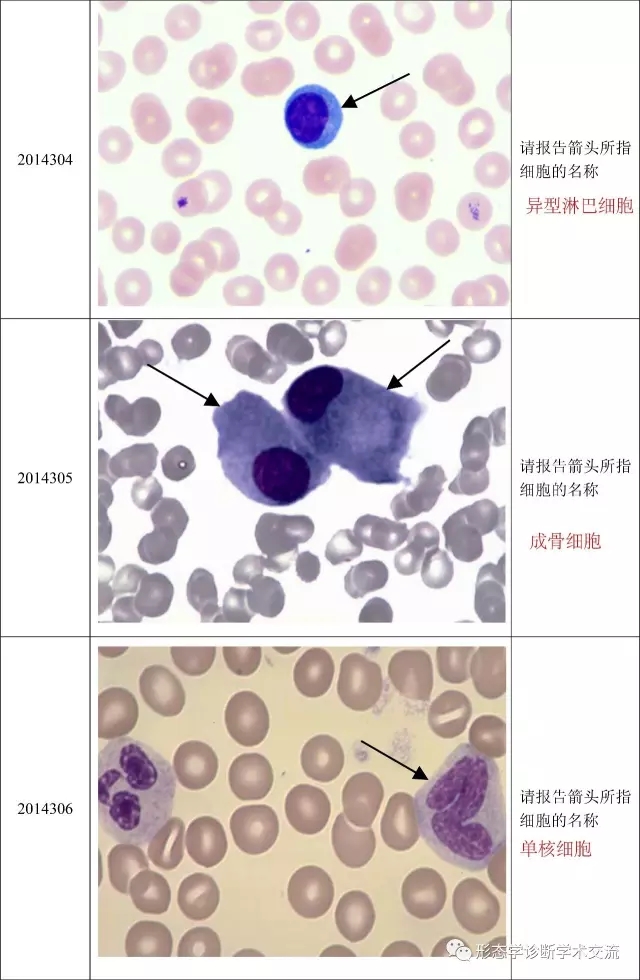
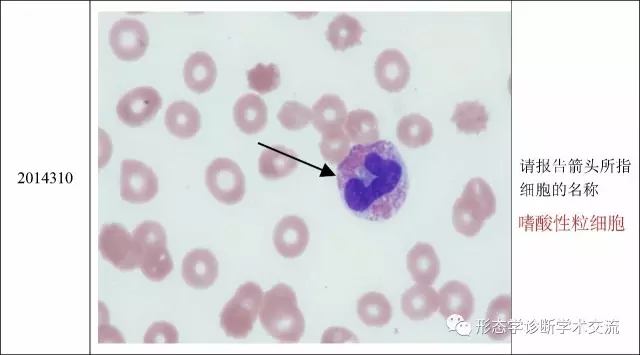
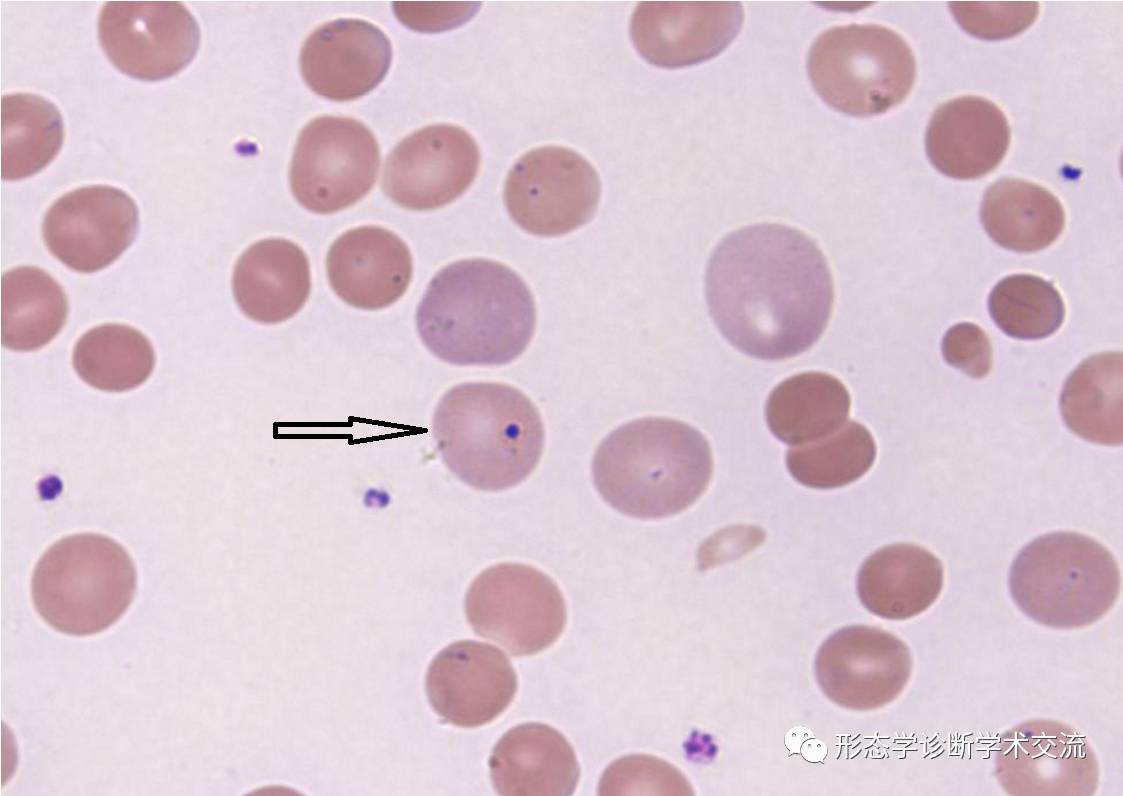
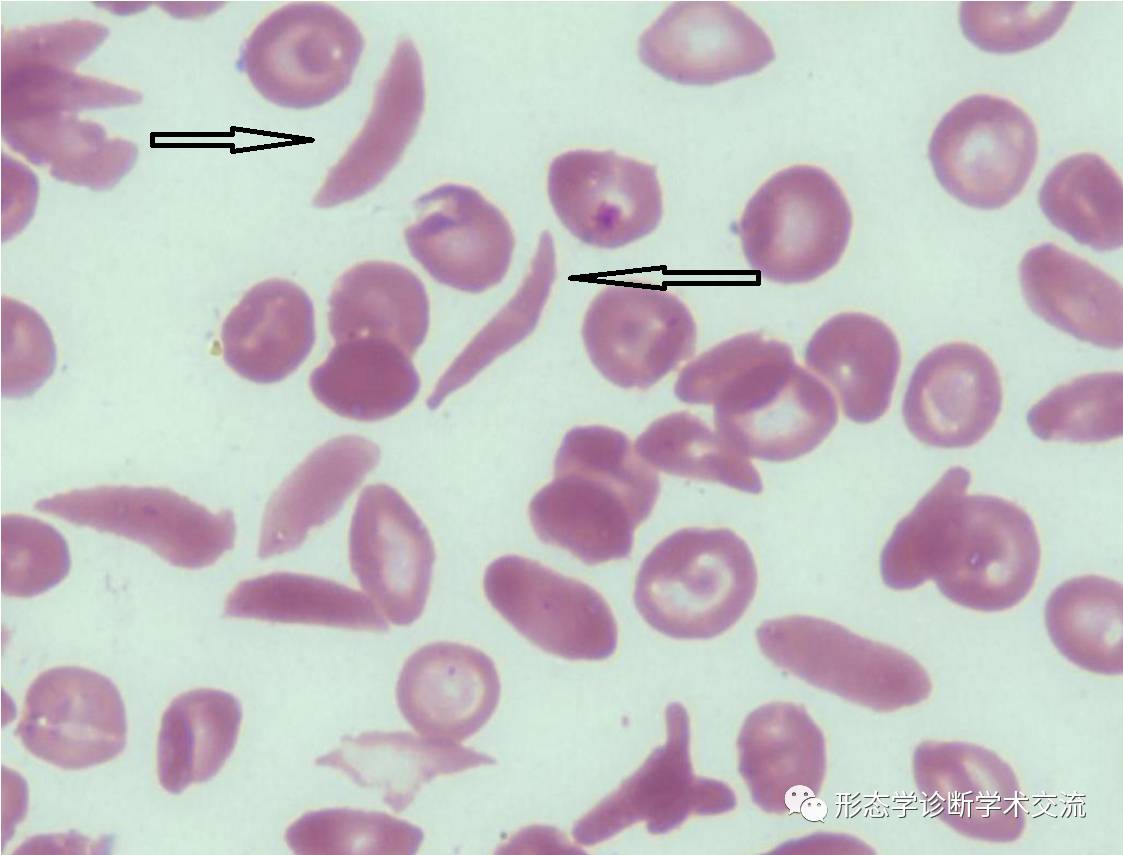
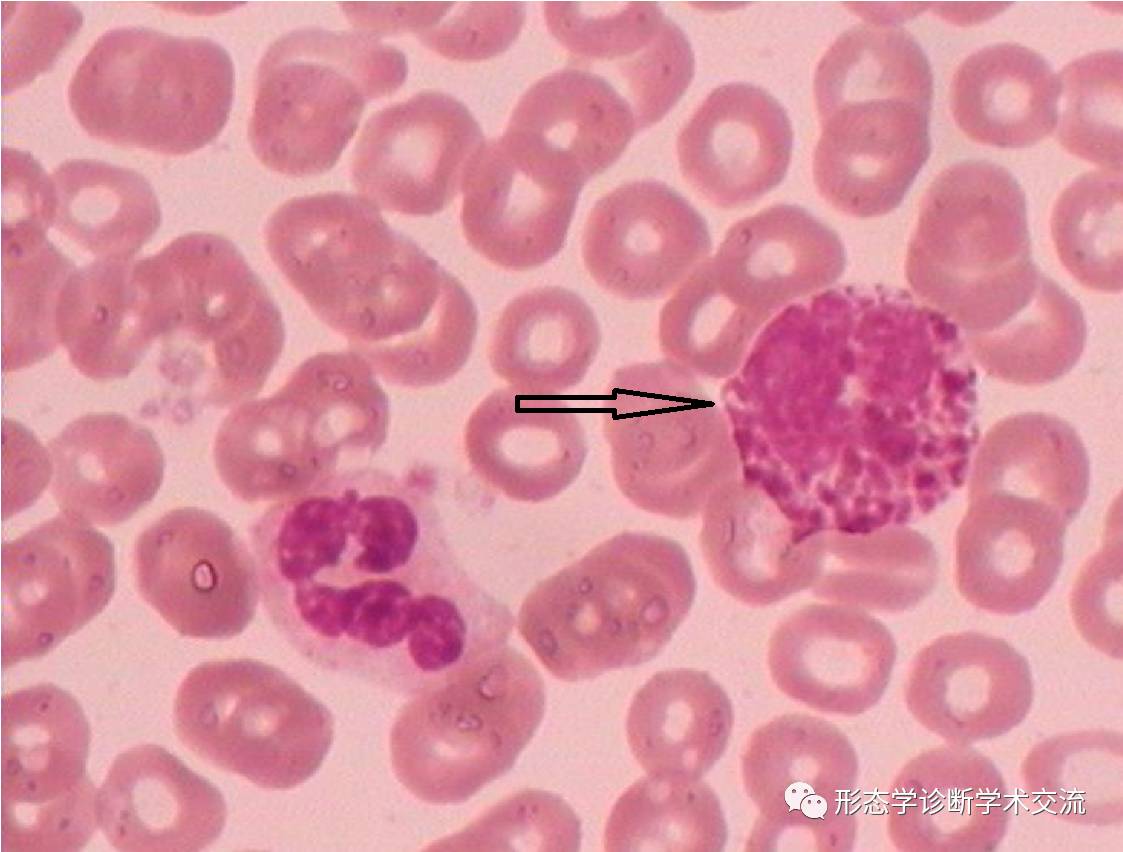
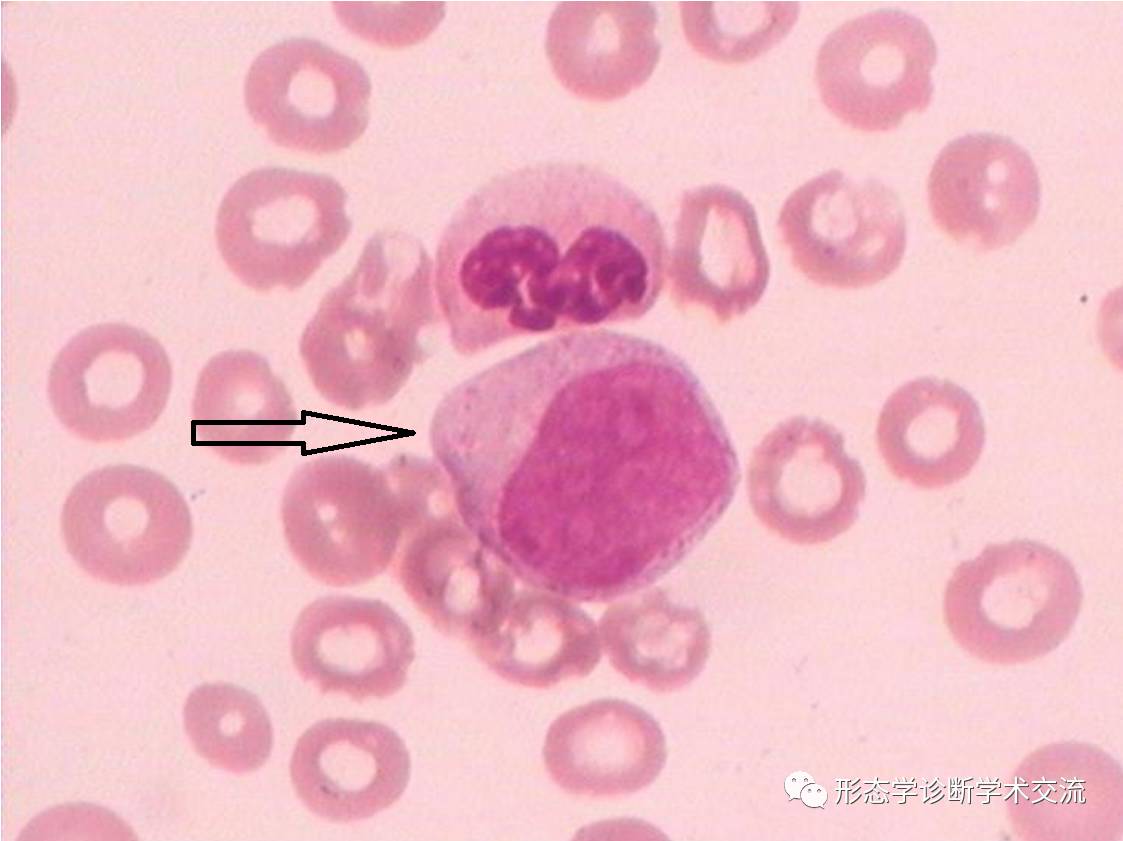
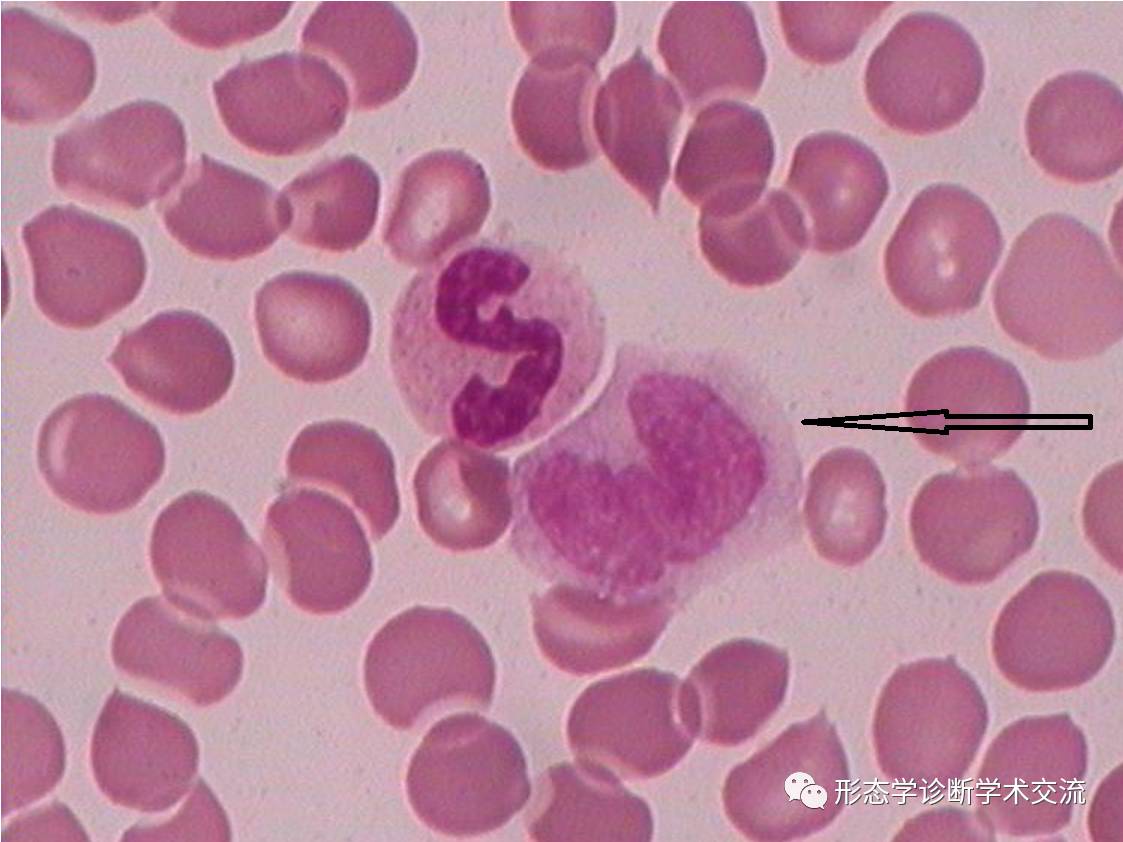
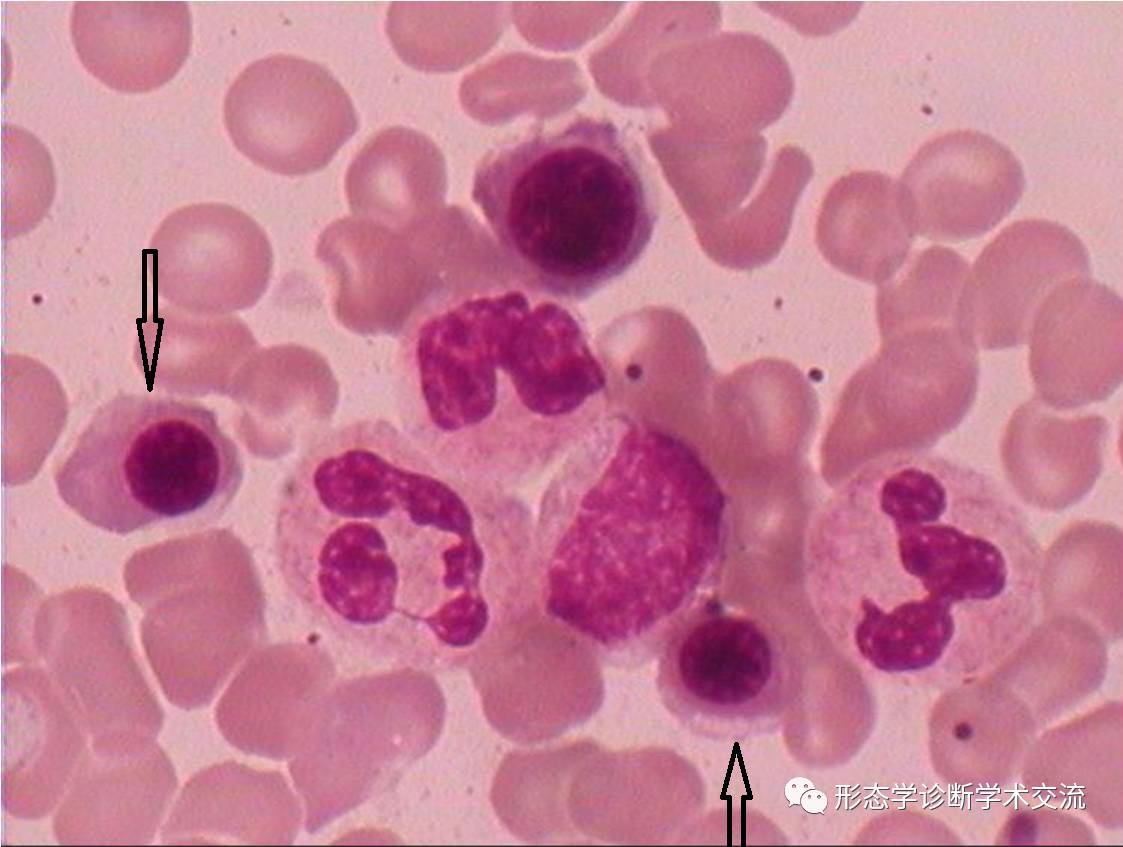
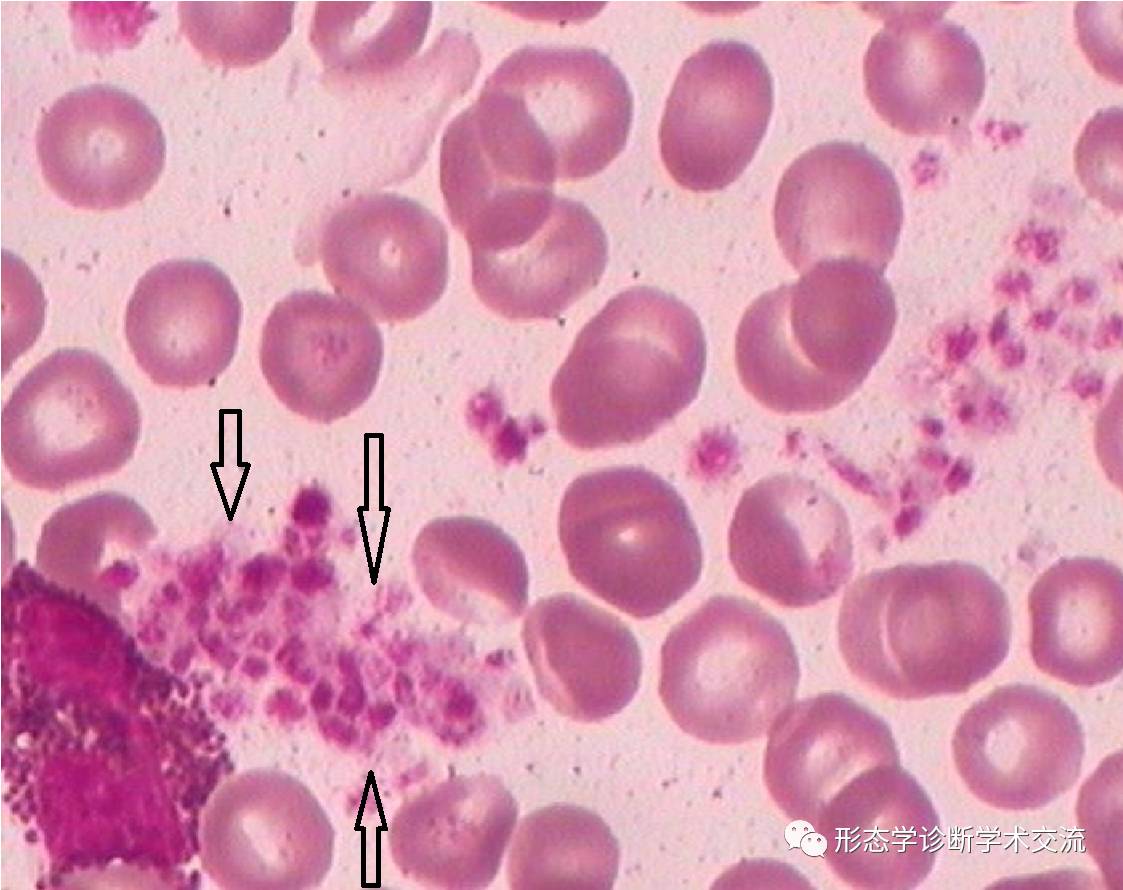
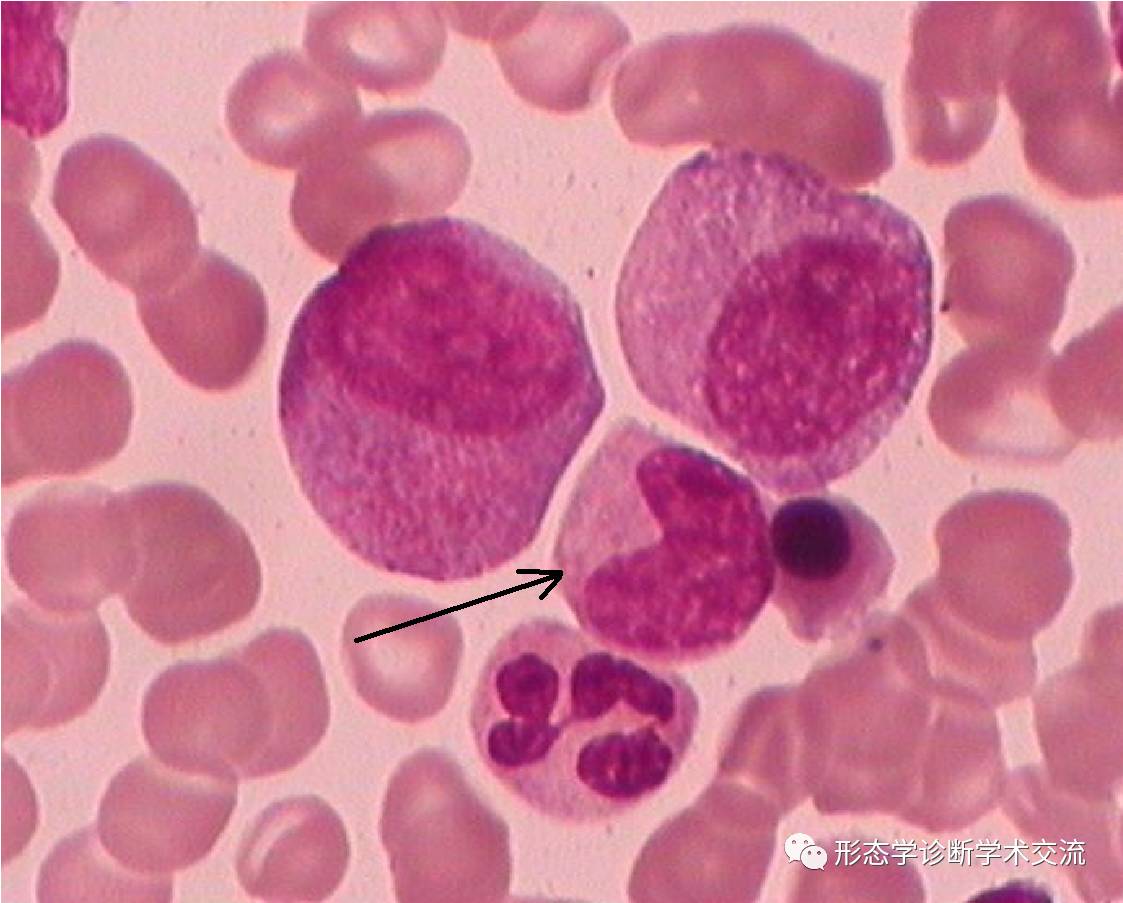
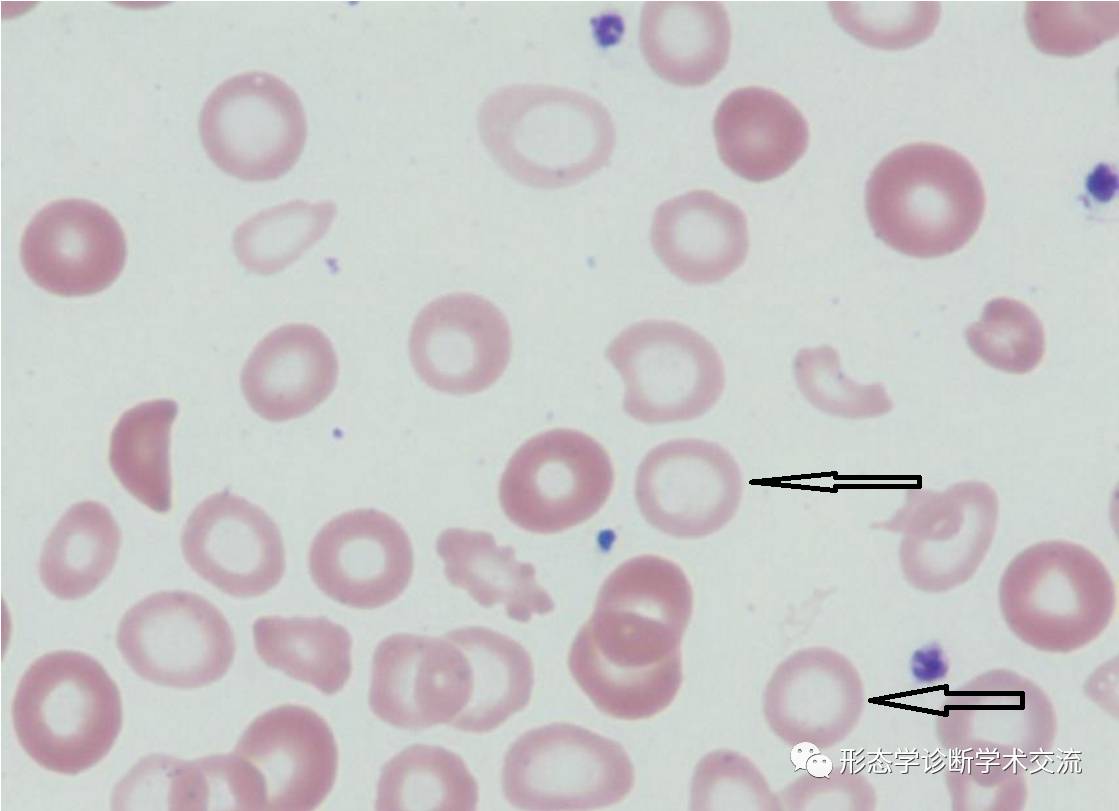
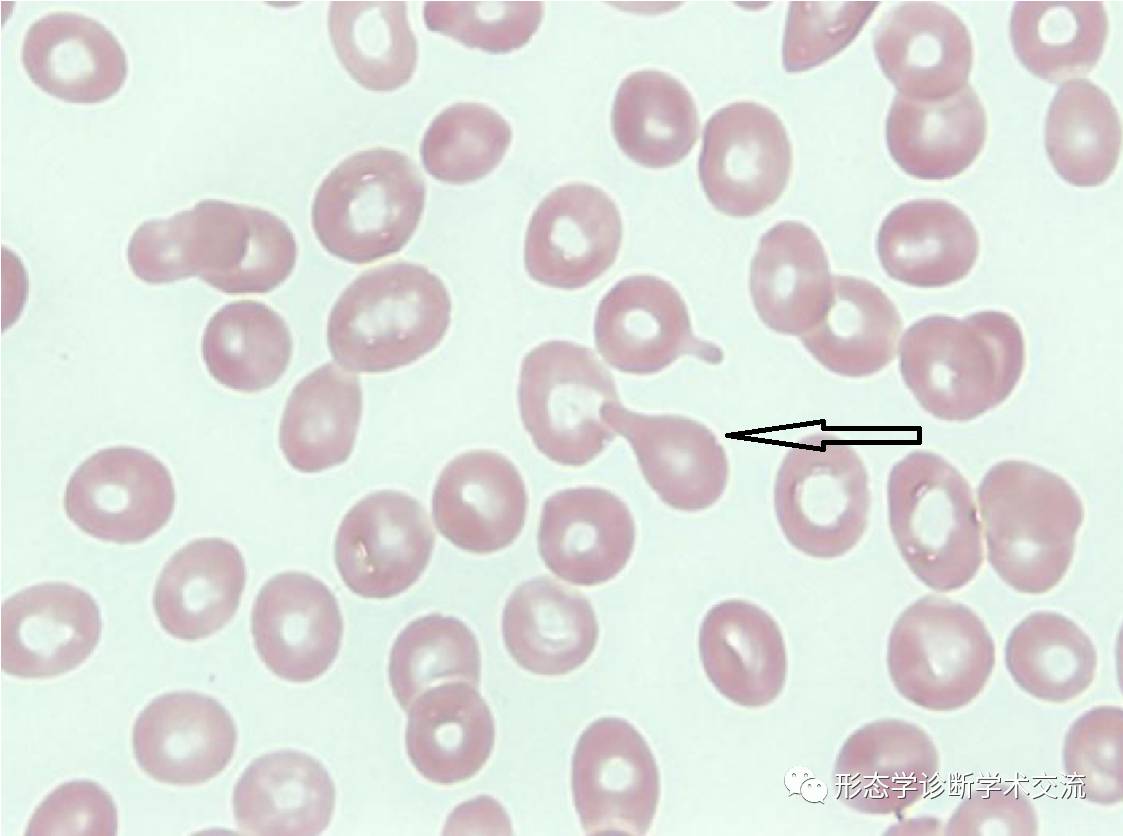
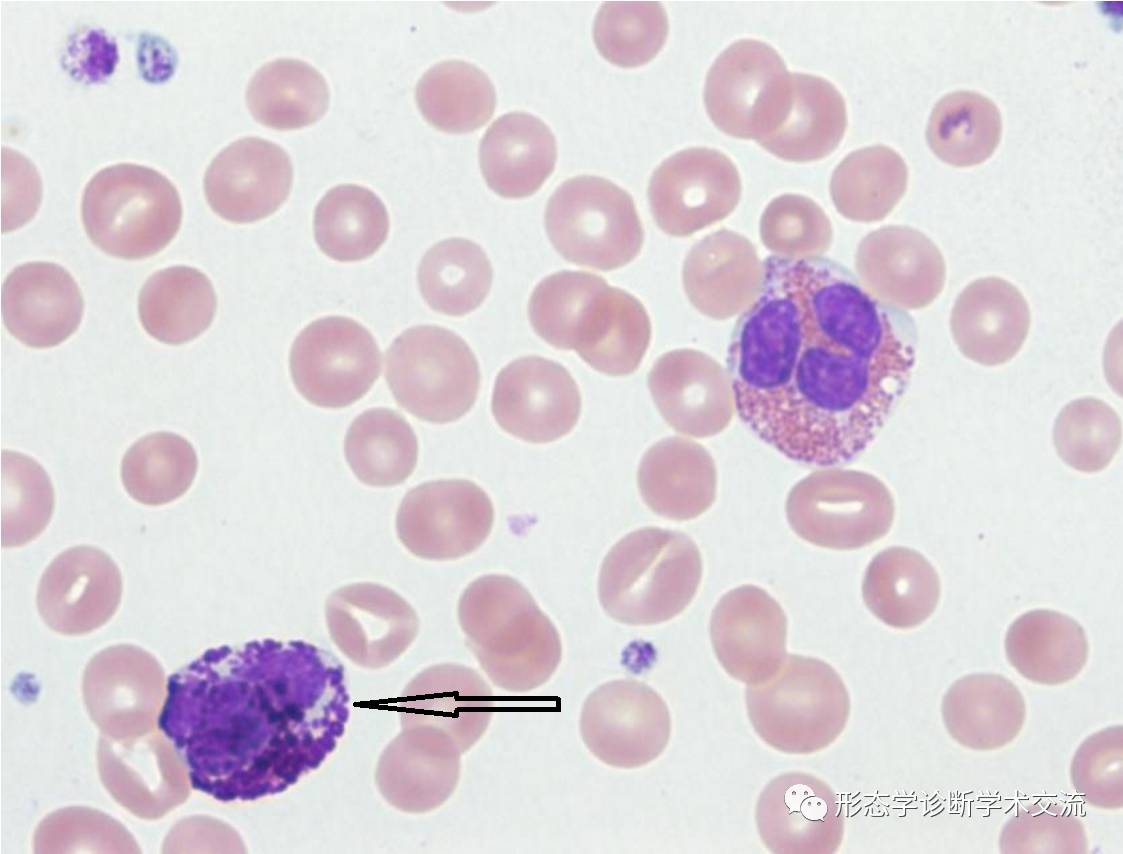
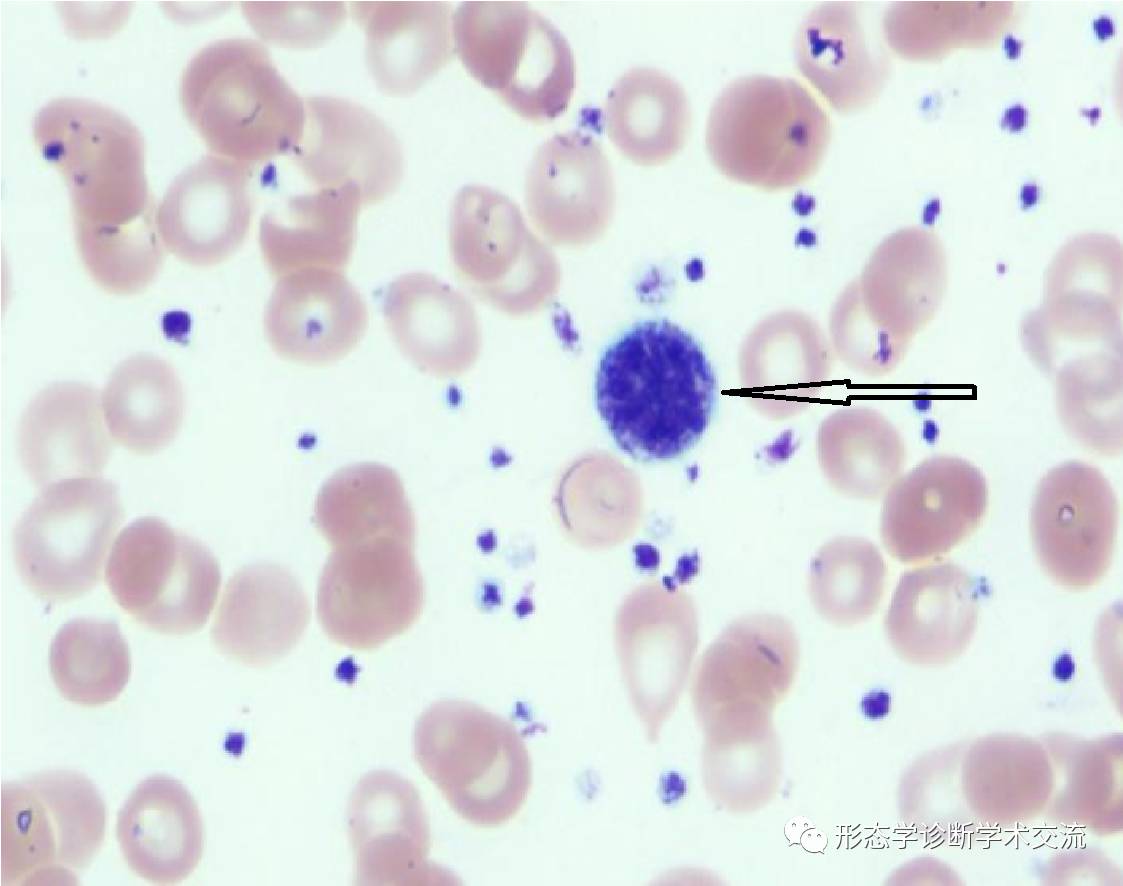
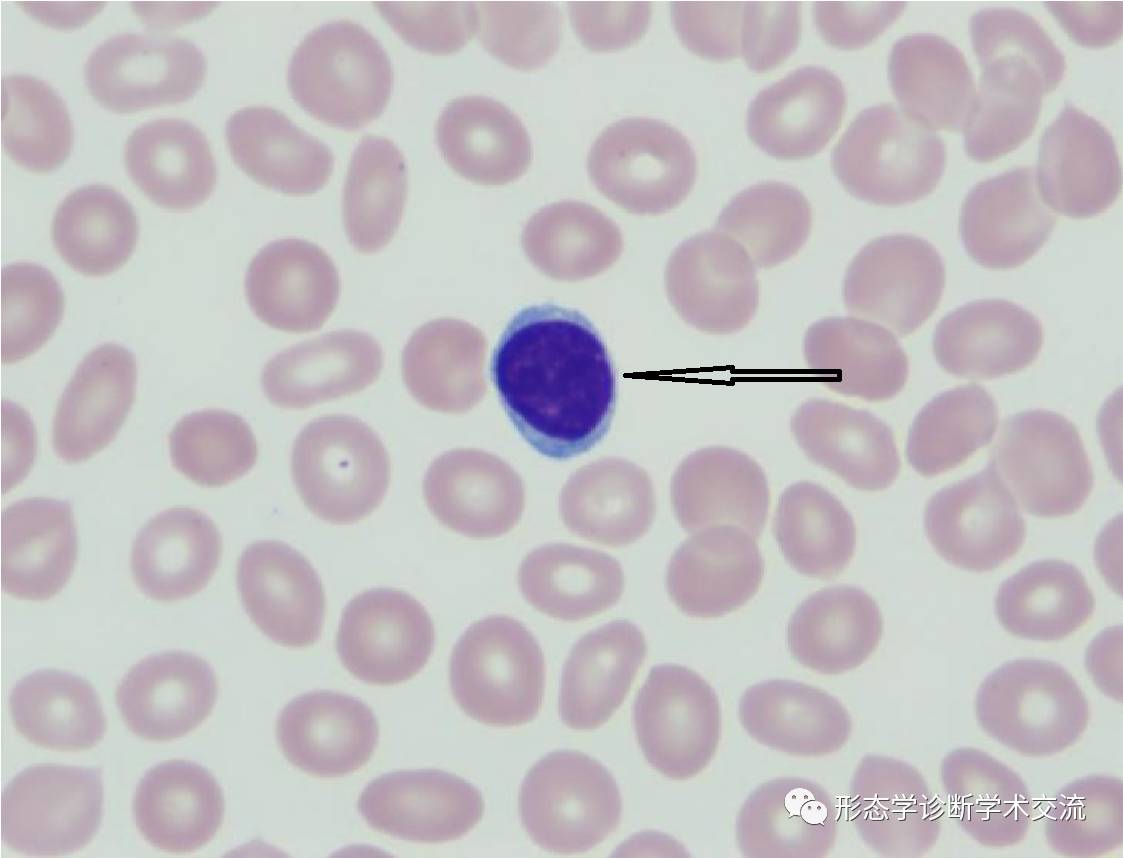
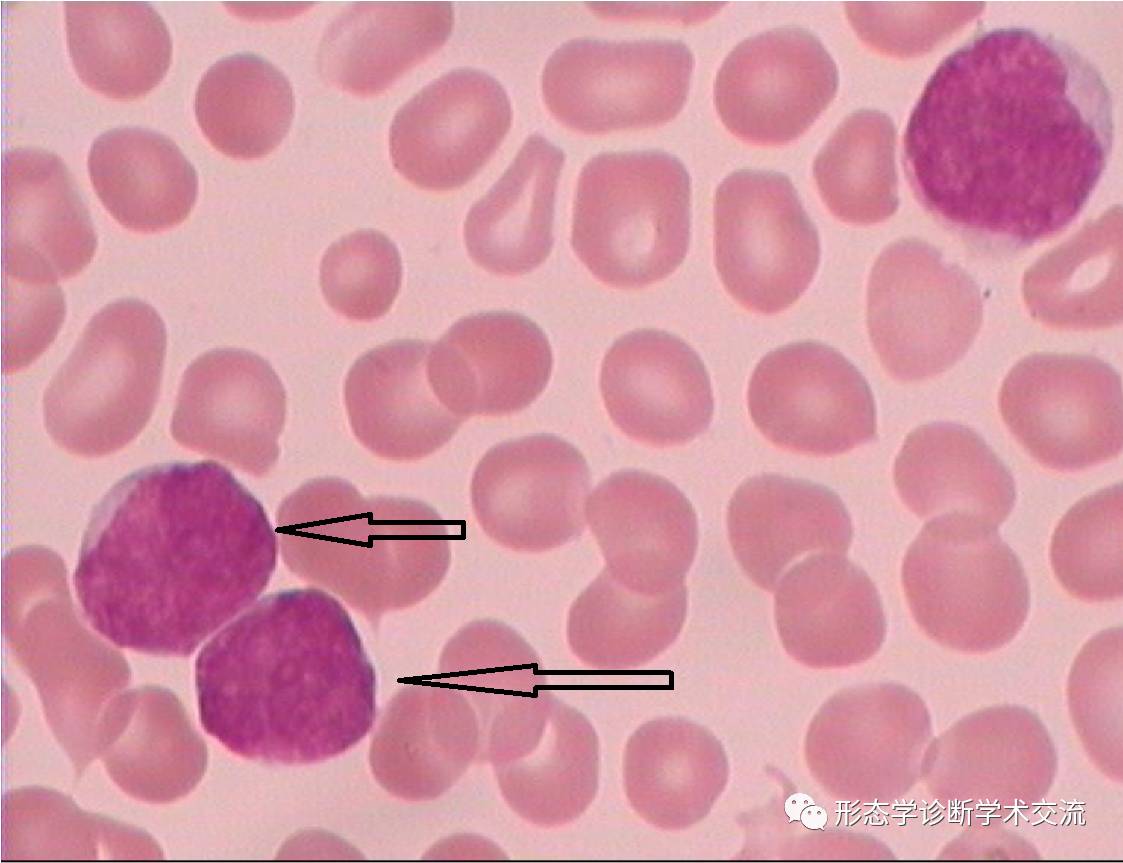
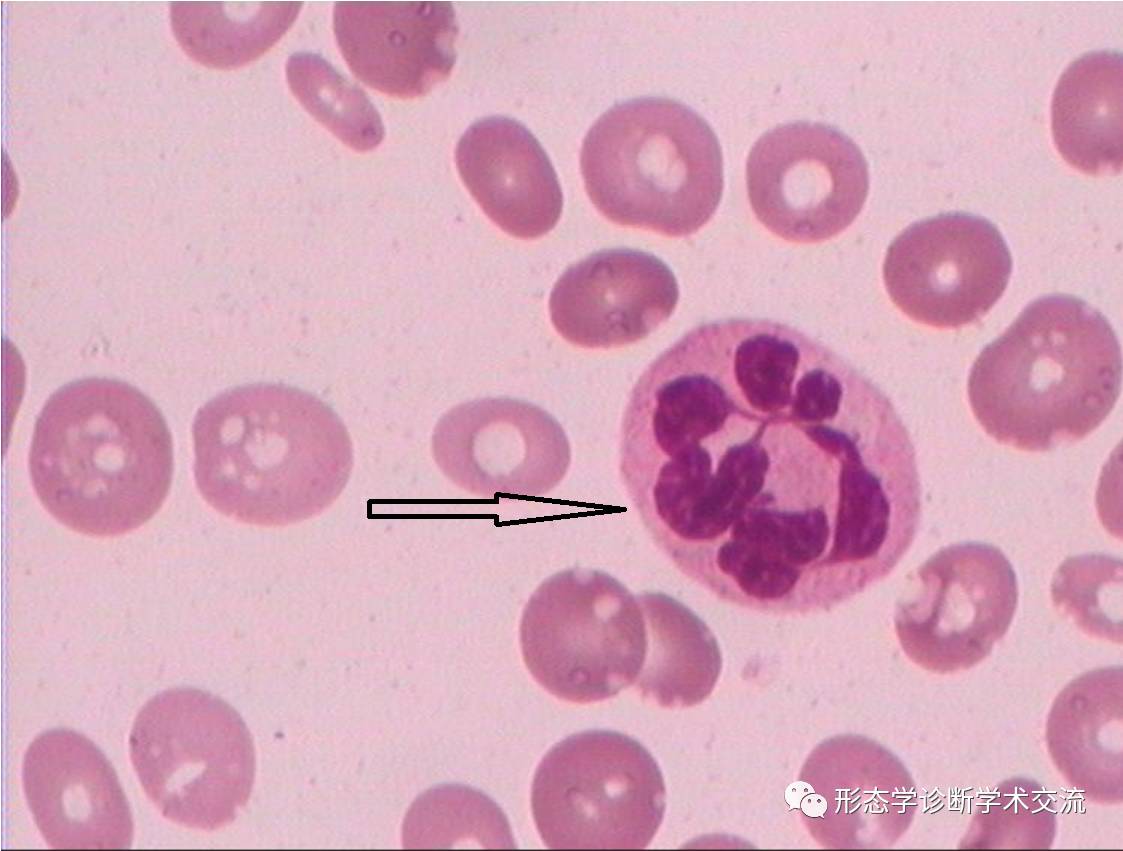
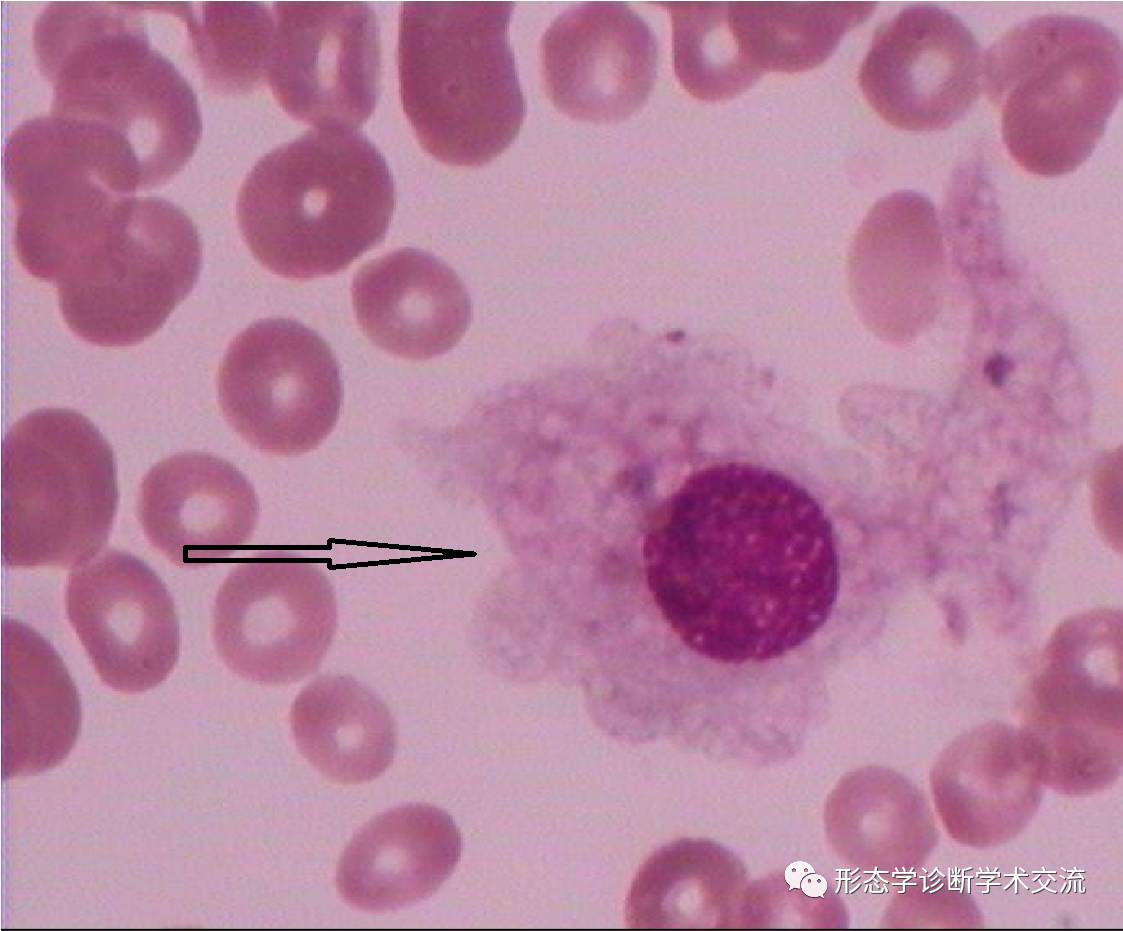
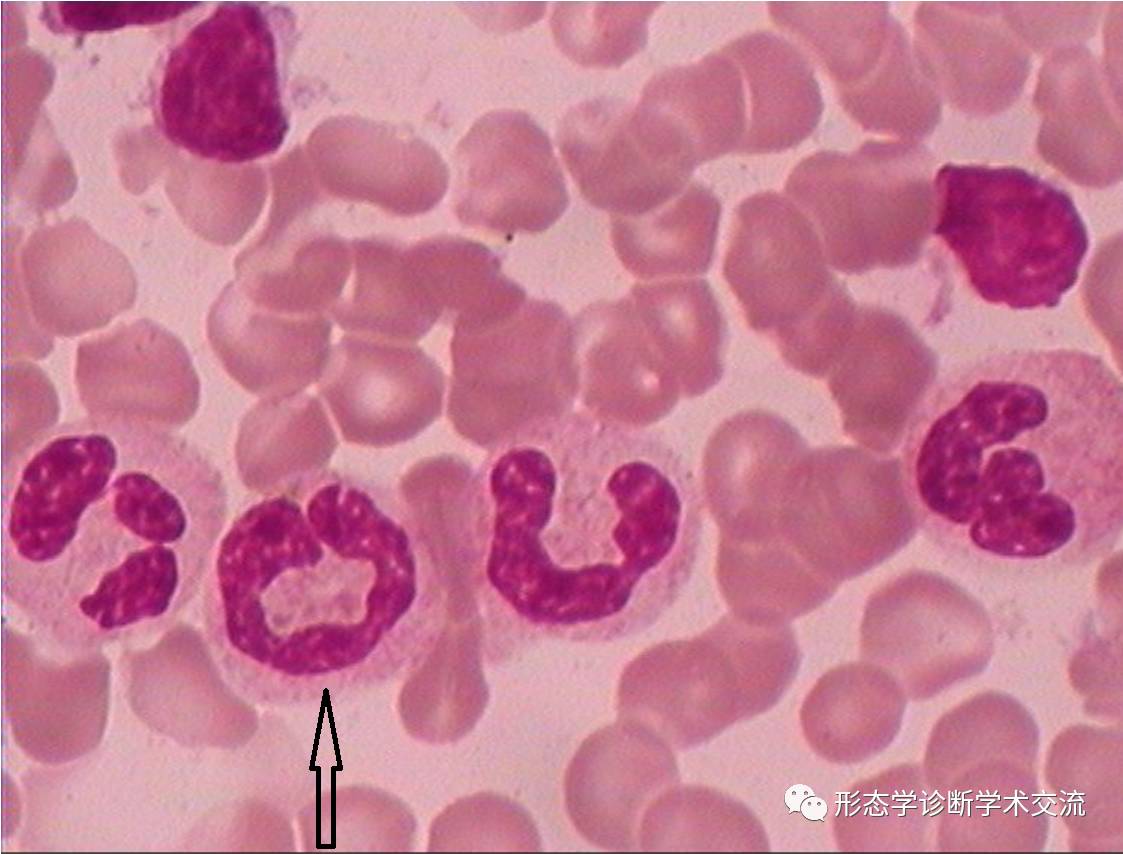
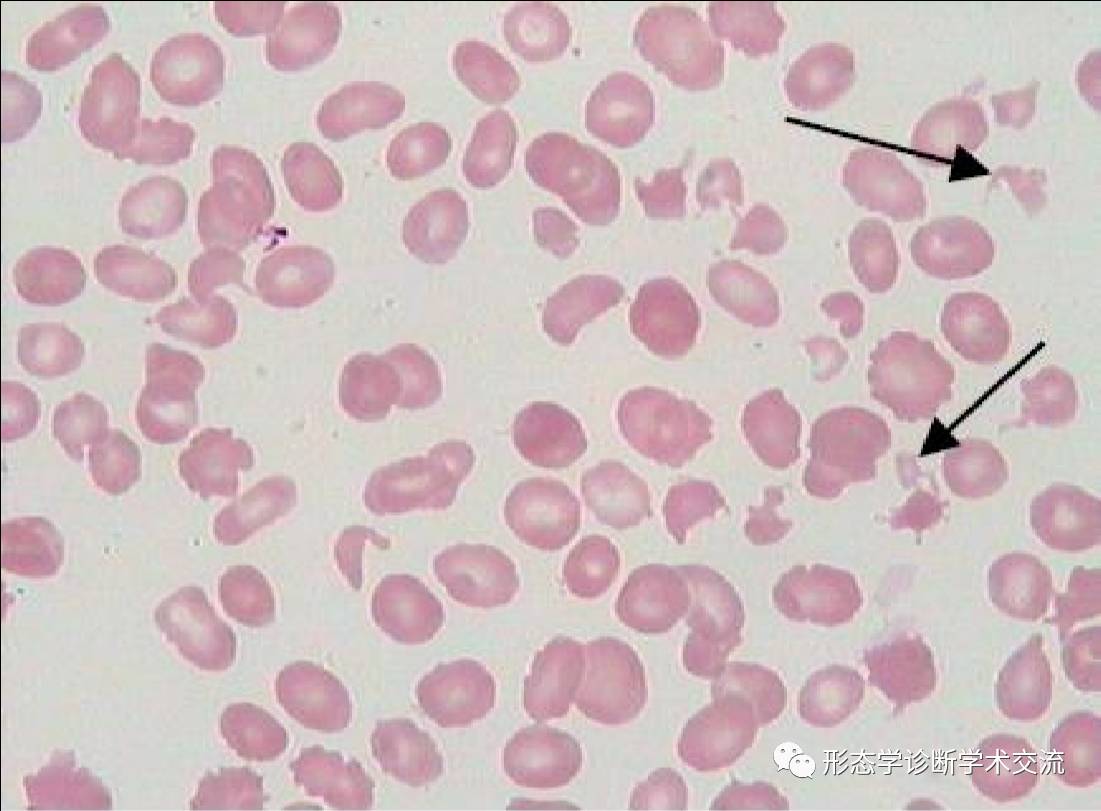
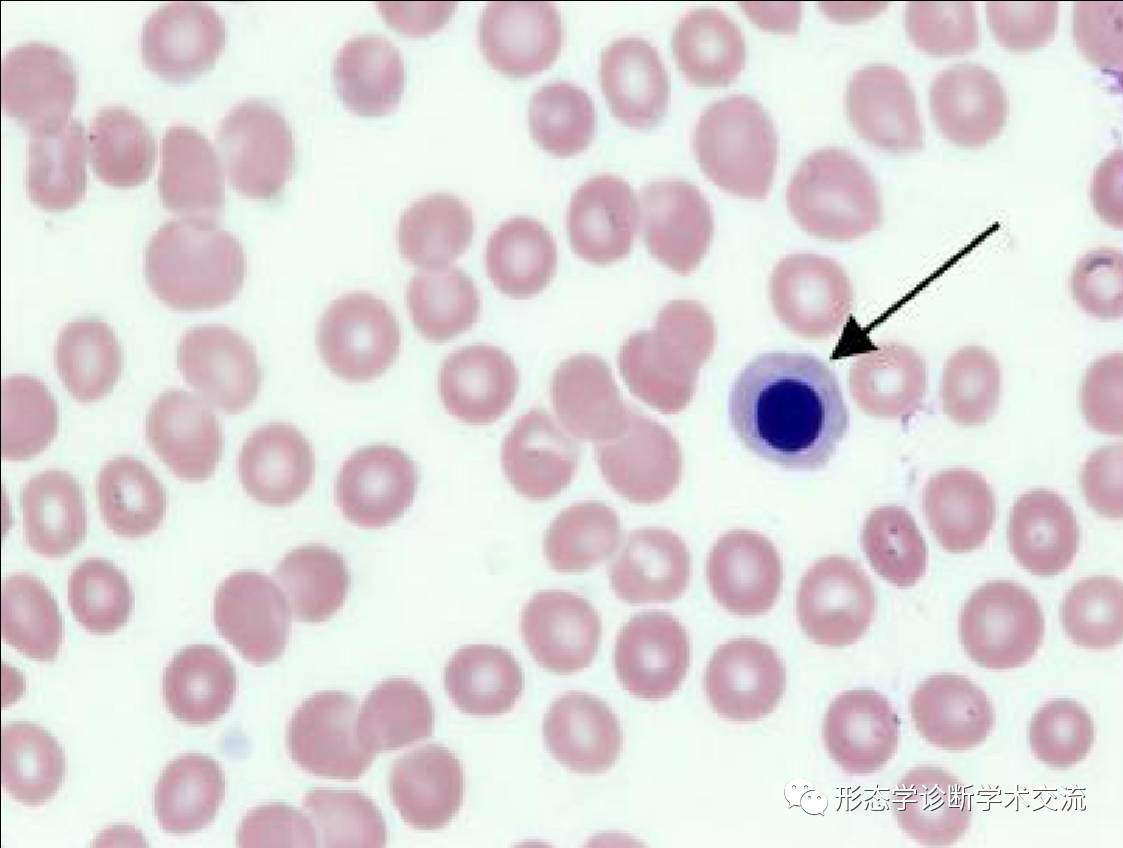
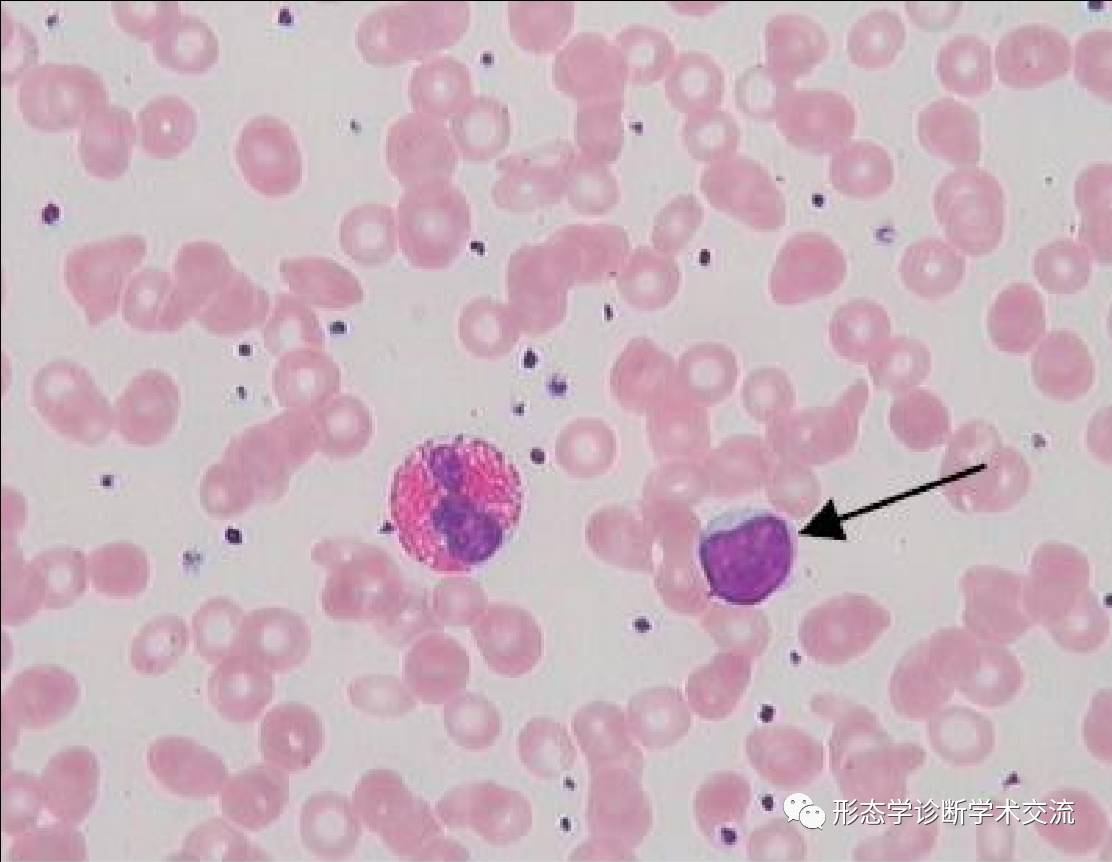
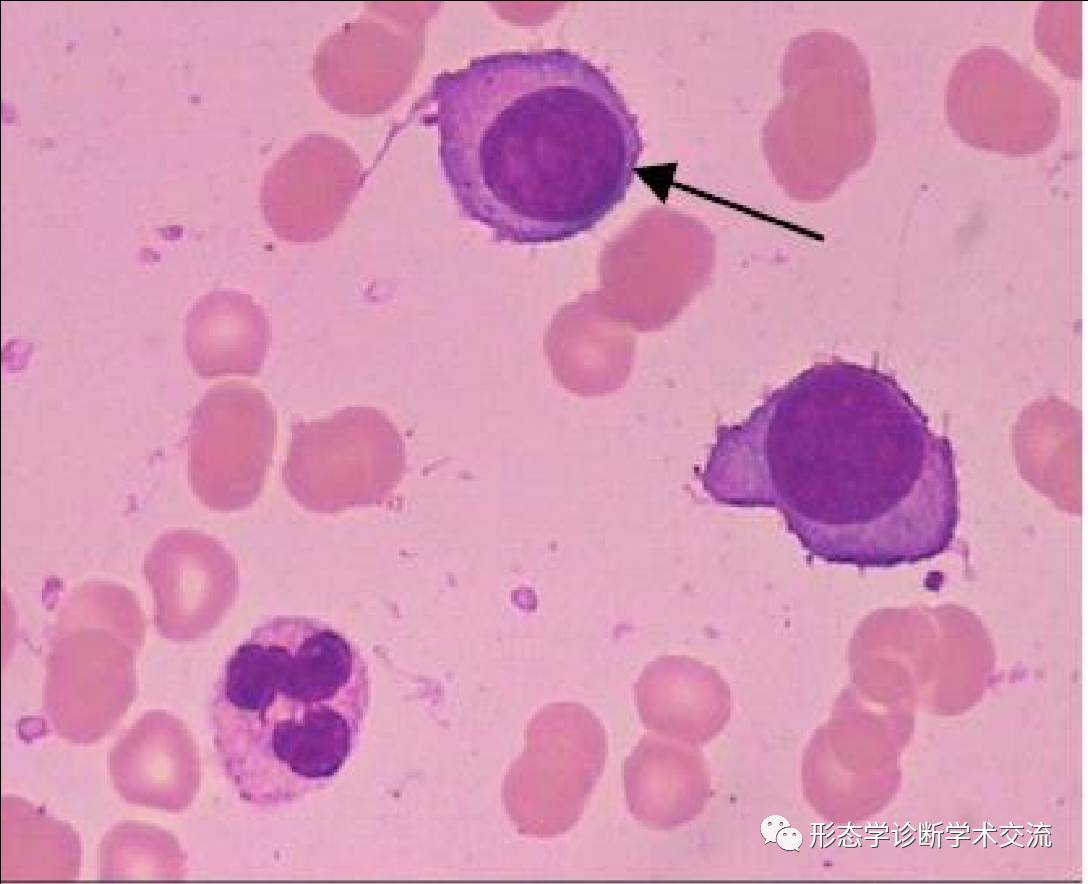
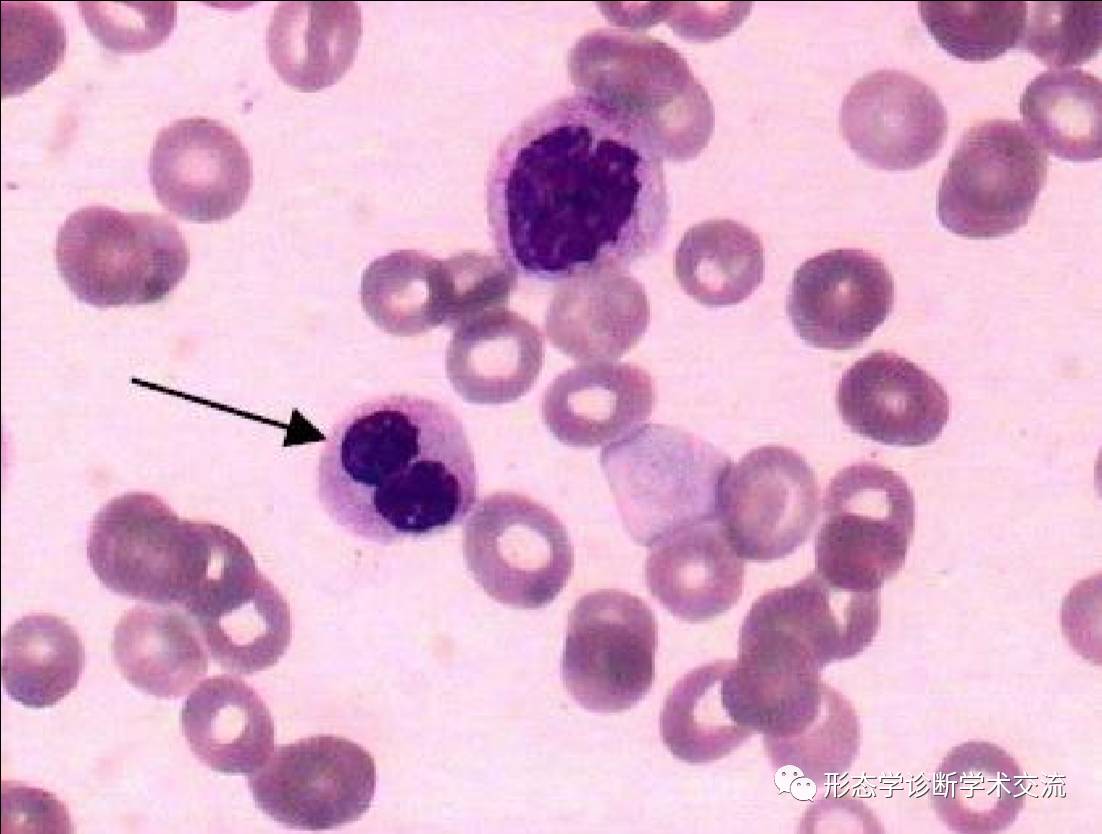
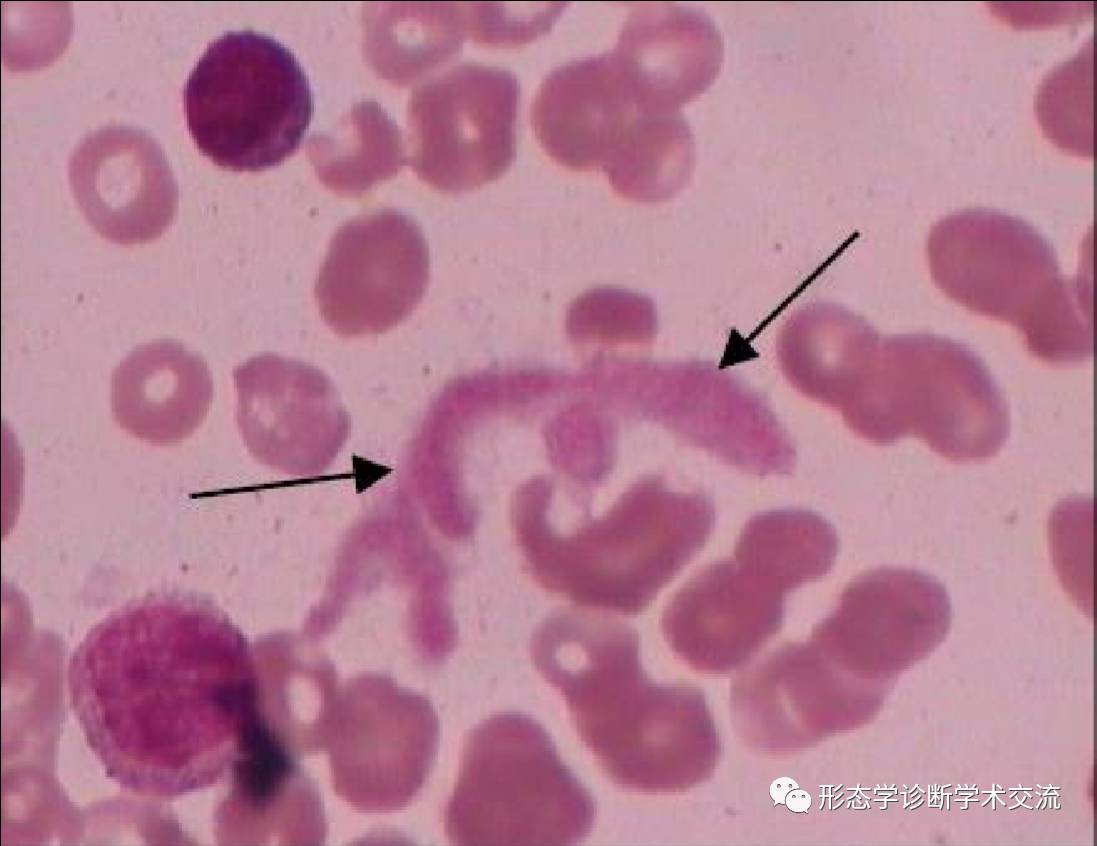
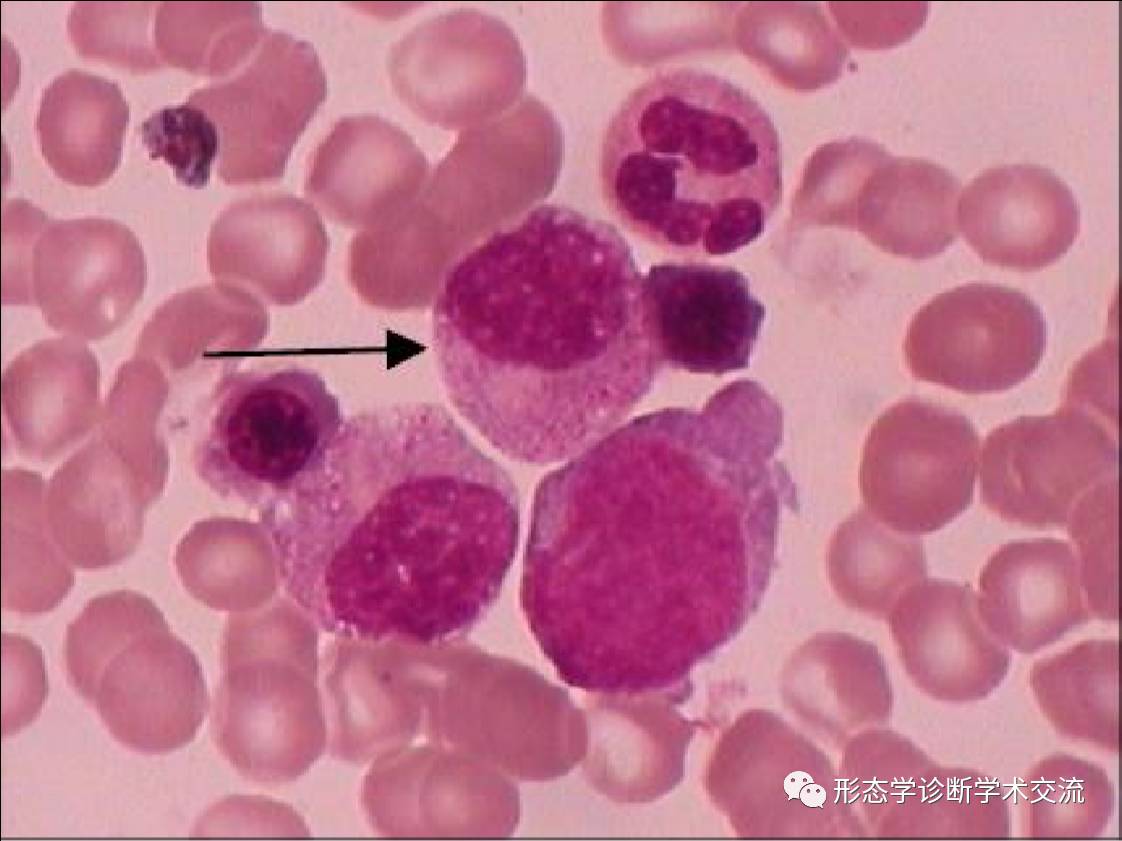
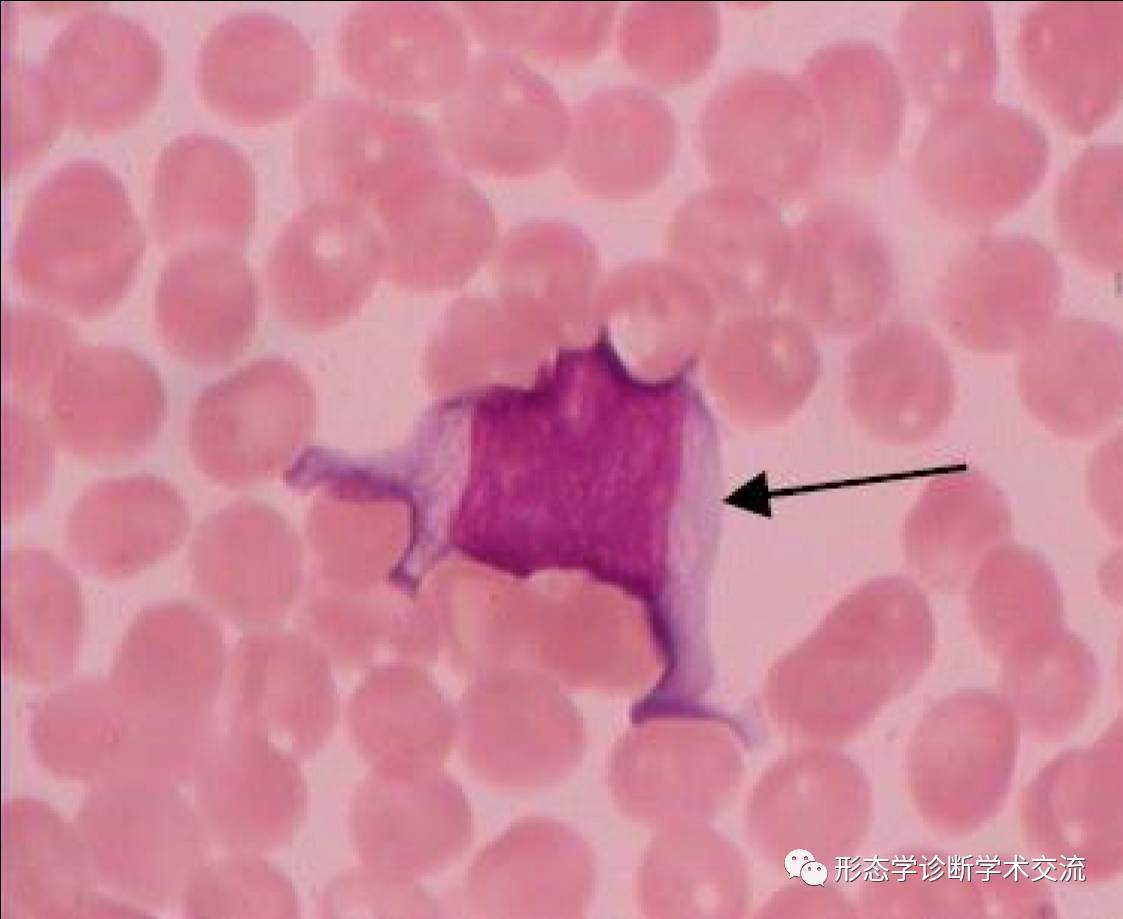
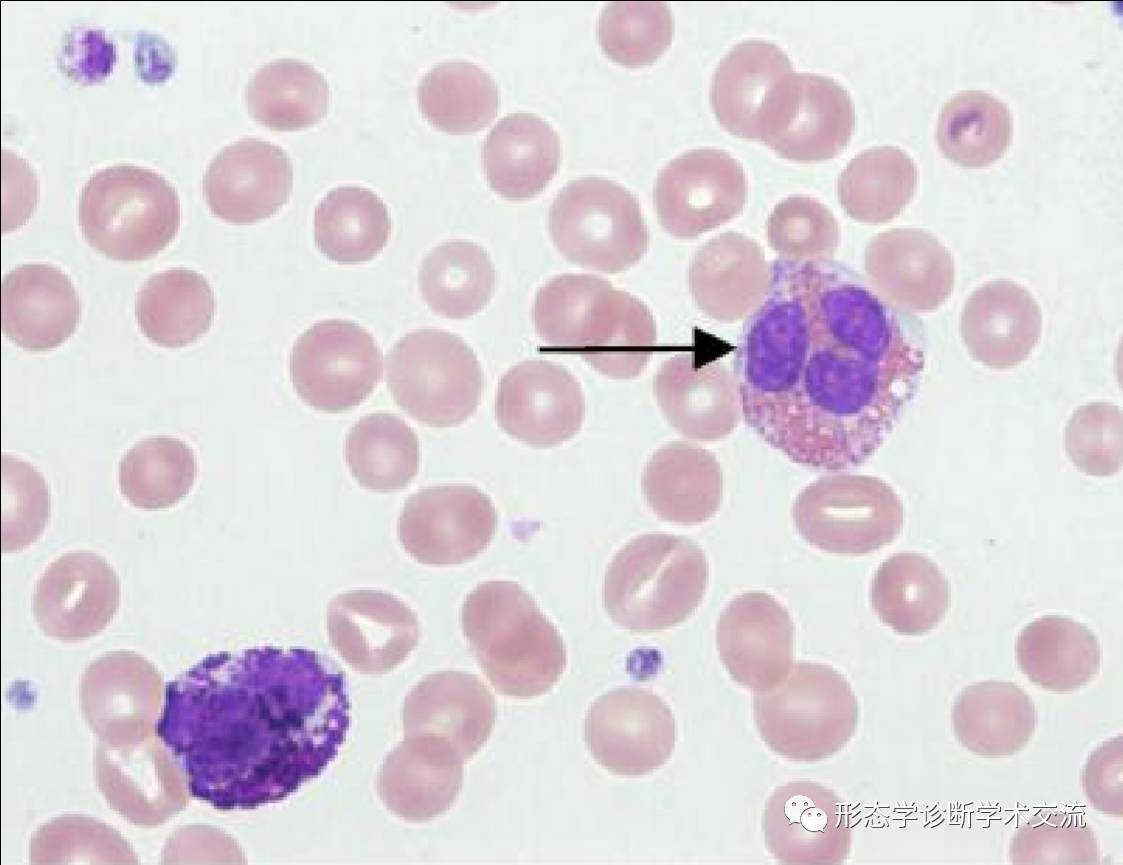

2013年血细胞形态学室间质量评价

2014年血细胞形态学室间质量评价

2015年血细胞形态学室间质量评价
2015年第1次血细胞形态检查室间质量评价
1.箭头所指细胞内结构的名称 Howell-Jolly小体
2.箭头所指细胞的名称 镰形红细胞

4.箭头所指物质的名称 畸形血小板,大血小板、巨血小板

5.箭头所指细胞的名称 原粒细胞,早幼粒细胞
6.箭头所指细胞的名称 单核细胞
7.箭头所指细胞的名称 晚幼红细胞
8.箭头所指现象的名称 血小板聚集
9.箭头所指细胞的名称 中性晚幼粒细胞
10.箭头所指细胞的名称 骨髓瘤细胞

11.箭头所指细胞的名称 低色素性小红细胞、红细胞中心淡染区扩大
12.箭头所指细胞的名称 泪滴形红细胞
13.箭头所指细胞的名称 嗜碱性粒细胞
14.箭头所指图像的名称 大血小板、巨血小板
15.箭头所指细胞的名称 淋巴细胞
16.箭头所指细胞的名称 原幼淋巴细胞
17.箭头所指细胞的名称 多分叶核中性粒细胞、巨多分叶中性粒细胞
18.箭头所指细胞的名称 原红细胞、早幼红细胞

19.箭头细胞的名称 巨噬细胞(组织细胞)
20.细胞的名称 中性杆状核细胞
21.箭头所指细胞的名称 裂片红细胞
22.箭头所指细胞的名称 晚幼红细胞
23.箭头所指细胞的名称 淋巴细胞
24.箭头所指细胞的名称 骨髓瘤细胞
25.箭头所指细胞的名称 佩耳格尔氏核异常(Pelger-Huet)细胞
26.箭头所指细胞的名称 畸形血小板,大血小板、巨血小板
27.箭头所指细胞的名称 中性中幼粒细胞
28.箭头所指细胞的名称 多分叶核中性粒细胞、巨多分叶中性粒细胞

29.箭头所指细胞的名称 异型淋巴细胞
30.箭头所指细胞的名称 嗜酸性粒细胞
来源:微信公众号“血液病综合诊断学术交流”